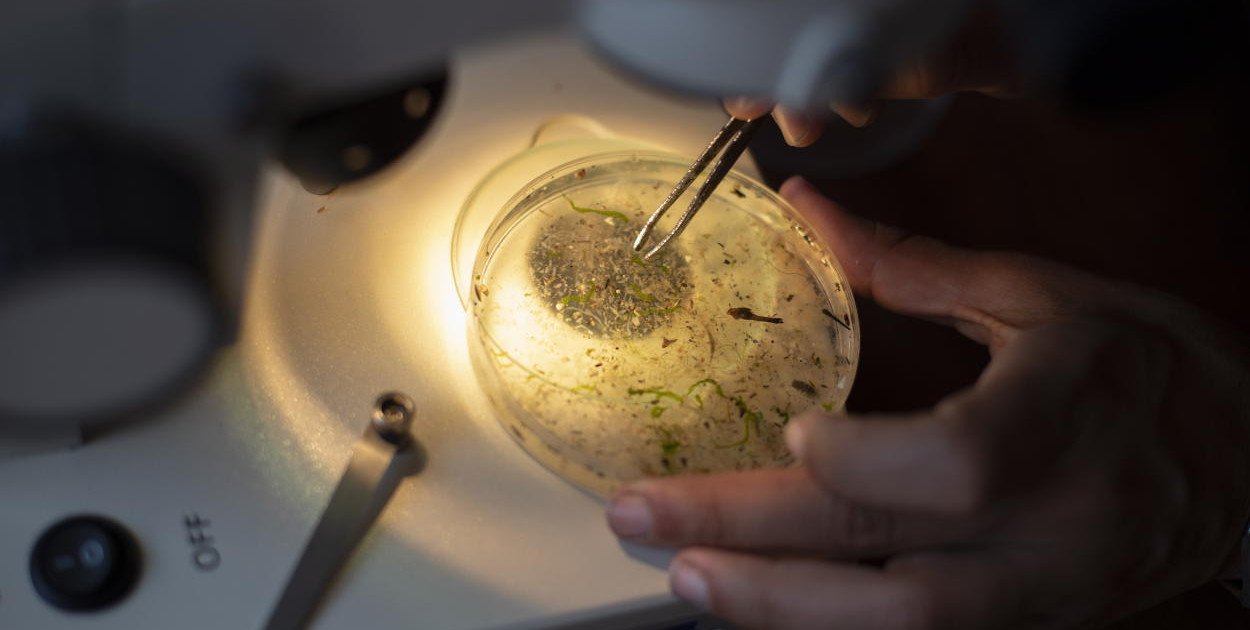

Prof. dr hab. Bożena Bukowska interesuje się m.in. chemicznymi zanieczyszczeniami środowiska, w tym występowaniem i toksycznością mikroplastiku. Prowadzi badania doświadczalne i przeglądowe. Jest autorką ponad 100 prac naukowych. Zajmuje się także działalnością popularyzatorską.
Mikro- i nanoplastik jest już wszędzie, choć w największych ilościach występuje w morzach i oceanach. Kolejne ogniwa łańcucha pokarmowego gromadzą te cząstki, aż trafiają one do ludzi. W otoczeniu człowieka istnieje dużo więcej źródeł mikroskopijnych plastikowych cząstek - mówi prof. dr hab. Bożena Bukowska z Katedry Biofizyki Skażeń Środowiska na Uniwersytecie Łódzkim.
PAP: Cząstki mikroplastiku wykrywa się w jedzeniu, wodzie, powietrzu, nawet na szczytach Alp. Mówimy o środowiskowym problemie - czy wręcz o ekologicznej katastrofie?
Prof. dr hab. Bożena Bukowska: W pewnym sensie, choć aż tak drastycznie może jeszcze nie trzeba tego, co się dzieje, oceniać. Ilość mikro- i nanoplastiku jest jednak w środowisku ogromna. Jeżeli wyhamujemy i będziemy zmierzali w kierunku zmniejszenia emisji tworzyw i recyklingu - to myślę, że tę degradację środowiska uda się wstrzymać. Na pewno ludzie zaczęli się zastanawiać nad tym, co zrobili. Podobnie zresztą działo się w przypadku innych substancji, na przykład pestycydów. Najpierw byliśmy nimi zachwyceni, wydawało się, że to coś wspaniałego i nieszkodliwego, potem ukazały się negatywne skutki ich stosowania.
Tak samo jest z plastikiem. Wydawało się, że znaleźliśmy materiał powszechnego zastosowania, łatwy i niedrogi w produkcji, nieprzepuszczalny dla wody. Teraz widzimy, że wszędzie można znaleźć plastikowe odpady i trudno je wyeliminować. Jednak na przykład Wielka Pacyficzna Plama Śmieci - choć jest ogromna - od jakiegoś czasu zajmuje podobną powierzchnię; nie zwiększa się. Może więc np. jakieś mikroorganizmy już ten plastik rozkładają. Bardzo ważny byłby potencjalny rozkład plastiku do nietoksycznych związków chemicznych, a nie jego rozpad do małych cząstek. Wiadomo bowiem, że pod wpływem czynników fizykochemicznych makroplastiki rozpadają się na mikrocząsteczki o średnicy mniejszej niż 5000 nm oraz nanocząstki o średnicy poniżej 100 nm.
PAP: Gdzie mikro- i nanoplastiku jest w środowisku najwięcej?
B.B.: Zdecydowanie najwięcej jest go w wodzie. Mowa głównie o morzach i oceanach, chociaż dotyczy to również rzek i lądowych zbiorników wodnych. Na przykład w północno-wschodniej części Pacyfiku znajdowanych jest ok. 9 tys. cząstek na metr sześcienny. To bardzo dużo.
PAP: Wiadomo, jakie szkody w środowisku powoduje?
B.B.: Największy problem jest taki, że cząstki te kumulują się w łańcuchu pokarmowym - gromadzą się w tkankach zwierząt. Powstało już na ten temat wiele prac. Przeanalizowano gromadzenie się plastiku w kolejnych ogniwach łańcucha - od zawieszonego w wodzie, przez glony, zooplankton, ryby. Wiele badań potwierdza, że w kolejnych organizmach stężenie cząstek rośnie. Jest to skutkiem konsumowania organizmów zawierających już znaczne ich ilości. Choć hałdy plastiku na plażach przerażają swoim widokiem, to najgroźniejszy jest ten plastik, którego gołym okiem nie widać.
Te drobne cząstki po wniknięciu do organizmu mogą powodować fizyczne uszkodzenia komórek i tkanek, doprowadzając do wielu zaburzeń w funkcjonowaniu organizmu. Mogą także być nośnikiem wirusów i bakterii oraz wektorem toksycznych chemikaliów, takich jak metale ciężkie i zanieczyszczenia organiczne. Jakie tkanki zostaną uszkodzone, to zależy od wielkości cząstek. Znaczna część mikroplastiku jest eliminowana z przewodu pokarmowego i układu oddechowego, nanoplastik - przeciwnie - w większym stopniu wnika do organizmu i dłużej pozostaje w tkankach.
PAP: Czy to prawda, że niektóre organizmy morskie mylą mikroplastik z drobinami pokarmu - i w efekcie się głodzą, albo że zaburza on pracę hormonów?
B.B.: Kolor i zapach tworzyw sztucznych (zwłaszcza przez porastające je glony) sprawia, że są one atrakcyjne dla zwierząt morskich. Drobiny plastiku są pokrywane przez wiele różnych mikroorganizmów, tworząc w ten sposób wielogatunkowe biofilmy, które stanowią zachęcające źródło pożywienia, ponieważ naśladują zapach ofiary. W konsekwencji plastik staje się pożywieniem i jak najbardziej może to skutkować brakiem kalorii i głodzeniem.
W cząstkach plastiku jako dodatki znajdują się związki o charakterze ksenoestrogenowym tzn. zaburzającym pracę hormonów, takie jak np. bisfenol A czy ftalany. Zatem pośrednio cząstki plastiku jako nośniki ksenoestrogenów również takie działanie mogą wykazywać.
Trzeba też podkreślić, że coraz więcej mówi się o wspomnianym nanoplastiku.
PAP: Czym on jest i dlaczego zwracamy na niego uwagę?
B.B.: Mikroplastik, po dostaniu się do organizmu, jest w większości z niego wydalany, ale mniejsze cząstki mikroplastiku oraz cząstki o wielkości poniżej 100 nm - czyli właśnie nanoplastik - przedostają się łatwo do wielu tkanek, nawet do mózgu. Szereg badań wskazuje na obecność mikro- i nanoplastiku we krwi ludzi. Mogą się zatem rozprzestrzenić po całym organizmie, przedostają się nawet do płodu, do łożyska i mogą powodować liczne szkody.
PAP: Na przykład jakie?
B.B.: Badania na rybach wskazują np. na zaburzenia w ich zachowaniu i fizjologii, takie jak zmiany rytmu serca czy behawioru. Może to wpływać na poszukiwanie pokarmu czy też problemy z unikaniem drapieżników. Wykrywa się też stany zapalne, uszkodzenia DNA, śmierć komórek. Szkodliwych procesów jest wiele.
PAP: To zapewne dotyczy też ludzi, prawda?
B.B.: Jak najbardziej. Jednak efekty pojawiające się u człowieka wyjątkowo trudno jest badać. Trzeba by porównywać stężenie plastiku w organizmach ludzi i obserwować różne reakcje. Nie spotkałam się jeszcze z takimi badaniami. To raczej kwestia przyszłości. Prowadzi się jednak eksperymenty na ludzkich komórkach.
PAP: Co z nich wynika?
B.B.: Chociażby w mojej katedrze prowadzimy badania na erytrocytach i limfocytach. Według uzyskanych przez nas wyników nanocząstki plastiku zaburzają m.in. pracę mitochondriów, wywołują apoptozę - czyli śmierć komórek, zwiększają powstawanie szkodliwych reaktywnych form tlenu, mogą się przyczyniać do uszkodzeń w DNA. Zmiany zależą od wielkości cząstek - im mniejsze, tym więcej szkodliwych efektów powodują. Nie ma jeszcze informacji o ich rakotwórczym działaniu, ale uszkodzenia DNA mogłyby na to wskazywać.
PAP: A jakie są sposoby na ochronę środowiska? Wspomniany przez panią wybór naturalnych zamienników dla plastiku to jedna z metod, ale czy takich materiałów jest wystarczająco dużo?
B.B.: Nie jestem specjalistką w tej dziedzinie, ale z tego, co się orientuję, prowadzone są różnego rodzaju działania na tym polu. Na przykład na Politechnice Gdańskiej zespół prof. Heleny Janik opracował zamiennik plastiku na bazie skrobi ziemniaczanej.
PAP: Problem może jednak polegać na tym, że takie materiały - podobnie jak recycling - będą stosowały tylko bogate kraje. W wielu miejscach na świecie śmieci wrzuca się prosto do rzeki czy oceanu.
B.B.: Mam nadzieję, że wszyscy się przebudzą, ale niestety, w biednych częściach świata ludzie mają inne priorytety i bardziej, niż przyszłość planety, interesuje ich to, co jest kluczowe dla przeżycia na chwilę obecną. Podobnie jest z produkcją plastiku. Na świecie wytwarza się go rocznie ok. 400 mln ton, z czego w Europie tylko 60 mln. Nawet, jeśli Europa zredukuje produkcję, ograniczenie to będzie dotyczyło tylko 15 proc. światowej produkcji.
PAP: Czy w międzyczasie można się samemu chronić?
B.B.: Przede wszystkim trzeba mieć na uwadze, gdzie tych cząstek jest najwięcej w otoczeniu człowieka. Ich duże ilości uwalniają się z ubrań ze sztucznych włókien. Dzisiaj 60-70 proc. ubrań szytych jest z syntetycznych materiałów. Dominuje poliester, nylon, poliamid, elastan, akryl.
Inne źródło plastikowych cząstek to herbata w torebkach. Prawie wszystkie torebki zawierają polipropylen, który nadaje im kształt. Po zaparzeniu, jak pokazują badania, z torebki uwalnia się bardzo dużo cząstek mikroplastiku i nanoplastiku.
Badania prowadzone na słodkowodnych stawonogach - rozwielitkach wskazały, że cząstki z torebek od herbaty zmieniały anatomię i zachowanie tych stworzeń. Lepszym wyborem będzie więc herbata sypana. Analogicznie lepiej unikać gotowania ryżu i kaszy w torebkach foliowych, choć na pewno jest to wygodniejsze.
Kolejna sprawa to woda. Praca przeglądowa Gambino i współpracowników z 2022 roku, podsumowująca 21 niezależnych badań, wskazuje na duży rozrzut ilości oznaczanych cząstek plastiku w wodzie pitnej. Wszystkie jednak uzyskane wyniki dokumentują większą ich ilość w wodzie butelkowanej niż kranowej.
PAP: Co więc robić, żeby dbać o zdrowie w kontekście wszechobecności mikroplastiku?
B.B: Lepiej jest pić wodę z kranu i jeszcze dodatkowo ją filtrować. Zamiast plastikowych słomek lepiej używać papierowych, szklanych czy metalowych. Zamiast korzystać z plastikowych sztućców i talerzyków, lepiej wybrać ich naturalne odpowiedniki np. wytwarzane z otrębów.
To nie wszystko. Warto uważać na kosmetyki i obecne w nich wtórne i pierwotne cząstki. Wtórne to te, które powstają ze ścierania się różnych plastikowych powierzchni, a pierwotne są dodawane do kosmetyku - np. do pasty do zębów, czy kremów do peelingu. Lepiej wybierać kosmetyki naturalne (np. peeling zawierający rozdrobione pestki owoców) niż cząsteczki syntetyczne. Dobrze jest też często odkurzać mieszkanie i myć podłogę. Cząstki mikro- i nanoplastiku lubią bowiem gromadzić się w kurzu. Kolejna sprawa, jeśli chodzi o mieszkanie, to wietrzenie. Wykazano, że więcej cząstek znajduje się w pomieszczeniach, niż na zewnątrz. (PAP)
Marek Matacz
mat/ zan/

0 0
Hello.
My name is Irina. I am an expert in posting articles and texts on various websites.
Would you be interested in mutual cooperation? In fact, I have to propose you something but before starting working answer please this questionnaire in the link below: https://forms.gle/58NDRfrHg3RMdRcW7
It takes no more than 3 minutes but will clarify all the details of the project and accelerate each stage of your future partnership.
Thank you in advance for your time and I’m looking forward to a fruitful collaboration.
If you require any further information about the questionnaire or anything else, feel free to contact me.
Best regards, Irina
0 0
Szanowny Odbiorco,
Czy zmagasz się z kłopotami wynikającymi z Twojego kredytu we frankach szwajcarskich (CHF)? Jesteśmy tutaj, aby przedstawić Ci profesjonalne pomoc prawną w tej złożonej sytuacji.
Nasza firma specjalizuje się w reprezentowaniu klientów, którzy borykają się z niesprawiedliwymi warunkami kredytów w CHF. Rozumiemy, jak obciążające mogą być te sprawy, dlatego zapewniamy:
- Dogłębną analizę Twojej sytuacji kredytowej
- Efektywną reprezentację w sporach z bankami
- Profesjonalne doradztwo prawne
- Spersonalizowane podejście do każdego przypadku
Nie pozwól, aby niejasności związane z Twoim kredytem CHF wpłynęły negatywnie na Twoje finanse. Nawiąż kontakt z nami już dziś, aby omówić Twoje opcje i zaplanować najlepszą strategię działania.
Odpowiedz na tę wiadomość lub wypełnij formularz na stronie: https://frankowypozew.pl
Z uprzejmymi pozdrowieniami,
Adam Broniewicz
0 0
Szanowny Kliencie,
Czy marzyłeś kiedykolwiek o stworzeniu niepowtarzalnej strony internetowej dla swojej firmy? Albo o otwarciu sklepu internetowego, który zaangażuje szerokie grono odbiorców?
Dzięki naszej ofercie, te marzenia mogą stać się faktem. Jesteśmy doświadczonym zespołem projektantów stron internetowych i sklepów online, którzy pomogli już wielu firmom takim jak Twój, spełnić ich cele.
Oferujemy:
- Całościowe wykonanie stron internetowych
- Intuicyjne rozwiązania e-commerce
- Ulepszenie pod kątem SEO
- Wsparcie techniczną i modernizacje strony
Jeśli jesteś zainteresowany rozpoczęciem swojej podróży w świecie online, prosimy o odpowiedź na tę wiadomość. Chętnie omówimy Twoje potrzeby i pokażemy spersonalizowaną ofertę.
Z poważaniem,
Monika
0 0
Hello.
My name is Irina. I am an expert in posting articles and texts on various websites.
Would you be interested in mutual cooperation? In fact, I have to propose you something but before starting working answer please this questionnaire in the link below: https://forms.gle/58NDRfrHg3RMdRcW7
It takes no more than 3 minutes but will clarify all the details of the project and accelerate each stage of your future partnership.
Thank you in advance for your time and I’m looking forward to a fruitful collaboration.
If you require any further information about the questionnaire or anything else, feel free to contact me.
Best regards, Irina
0 0
Hello.
My name is Irina. I am an expert in posting articles and texts on various websites.
Would you be interested in mutual cooperation? In fact, I have to propose you something but before starting working answer please this questionnaire in the link below: https://forms.gle/58NDRfrHg3RMdRcW7
It takes no more than 3 minutes but will clarify all the details of the project and accelerate each stage of your future partnership.
Thank you in advance for your time and I’m looking forward to a fruitful collaboration.
If you require any further information about the questionnaire or anything else, feel free to contact me.
Best regards, Irina
Użytkowniku, pamiętaj, że w Internecie nie jesteś anonimowy. Ponosisz odpowiedzialność za treści zamieszczane na portalu chocianow.com.pl. Dodanie opinii jest równoznaczne z akceptacją Regulaminu portalu. Jeśli zauważyłeś, że któraś opinia łamie prawo lub dobry obyczaj - powiadom nas [email protected] lub użyj przycisku Zgłoś komentarz